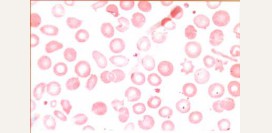
Дефект мембраны эритроцитов: микроцитоз, овалоцитоз, акантоцитоз – причины, симптомы и лечение

Содержание статьи:
 Эритремия (синонимы - истинная полицитемия, болезнь Вакеза-Ослера) – заболевание опухолевой природы, являющееся одной из разновидностей хронических лейкозов (опухолевых заболеваний системы крови). Характеризуется увеличением в крови преимущественно эритроцитов (а также, в той или иной степени, других клеток крови - тромбоцитов и лейкоцитов), повышением уровня гемоглобина, увеличением объема циркулирующей крови.
Эритремия (синонимы - истинная полицитемия, болезнь Вакеза-Ослера) – заболевание опухолевой природы, являющееся одной из разновидностей хронических лейкозов (опухолевых заболеваний системы крови). Характеризуется увеличением в крови преимущественно эритроцитов (а также, в той или иной степени, других клеток крови - тромбоцитов и лейкоцитов), повышением уровня гемоглобина, увеличением объема циркулирующей крови.Для данной болезни крови характерно относительно длительное и доброкачественное течение, не исключающее, однако, злокачественного перерождения в острый лейкоз со смертельным исходом.
Эритремия считается довольно редким заболеванием и встречается с частотой 4 – 7 случаев на 100 миллионов населения в год. Болеют, преимущественно, люди среднего и пожилого возраста (старше 50 лет), однако были зарегистрированы случаи болезни и в более раннем возрасте. Мужчины и женщины заболевают с одинаковой частотой.
Интересные факты
- Эритроциты составляют около 25% всех клеток человеческого организма.
- Каждую секунду в костном мозге образуется около 2,5 миллионов новых эритроцитов. Примерно столько же разрушается во всем организме.
- Красный цвет эритроцитам придает железо, входящее в состав гемоглобина.
- Эритремия является одним из самых доброкачественных опухолевых процессов крови.
- Эритремия может протекать бессимптомно в течение многих лет.
- Пациенты с эритремией склонны к обильным кровотечениям, несмотря на то, что количество тромбоцитов (отвечающих за остановку кровотечений) повышено.
Что такое эритроциты?
 Эритроциты (красные кровяные тельца) – наиболее многочисленные клетки крови, основной функцией которых является осуществление газообмена между тканями организма и окружающей средой.
Эритроциты (красные кровяные тельца) – наиболее многочисленные клетки крови, основной функцией которых является осуществление газообмена между тканями организма и окружающей средой.Структура и функции эритроцитов
По форме эритроцит представляет собой двояковогнутый диск, средний диаметр которого равен 7,5 – 8,3 микрометра (мкм). Важной особенностью данных клеток является их способность сворачиваться и уменьшаться в размерах, что позволяет им проходить через капилляры, диаметр которых равен 2 – 3 мкм.Нормальное количество эритроцитов в крови различается в зависимости от пола.
Норма эритроцитов составляет:
- у женщин – 3,5 – 4,7 х 1012 в 1 литре крови;
- у мужчин – 4,0 – 5,0 х 1012 в 1 литре крови.
Процесс транспортировки газов происходит следующим образом:
- В легочных капиллярах (тончайших кровеносных сосудах) к железу, входящему в состав гемоглобина, присоединяется молекула кислорода (образуется окисленная форма гемоглобина – оксигемоглобин).
- Из легких с током крови эритроциты переносятся в капилляры всех органов, где происходит отделение молекулы кислорода от оксигемоглобина и переход ее в клетки тканей организма.
- Взамен к гемоглобину присоединяется углекислый газ, выделяемый тканями (образуется комплекс, называемый карбгемоглобином).
- При прохождении эритроцитов, содержащих карбгемоглобин, через легочные капилляры происходит отсоединение углекислого газа от гемоглобина и выделение его с выдыхаемым воздухом, а взамен присоединяется очередная молекула кислорода и цикл повторяется.
Норма гемоглобина составляет:
- у женщин – 120 – 150 грамм/литр;
- у мужчин – 130 – 170 грамм/литр.
Где образуются эритроциты?
Образование эритроцитов происходит постоянно и непрерывно, начиная с 3 недели внутриутробного развития эмбриона и до конца жизни человека. Основными органами кроветворения у плода являются печень, селезенка и тимус (вилочковая железа).Начиная с 4 месяца эмбрионального развития появляются очаги кроветворения в красном костном мозге, который является основным кроветворным органом после рождения ребенка и на протяжении всей жизни. Общий его объем у взрослого человека составляет около 2,5 – 4 кг и распределен в различных костях организма.
У взрослого человека красный костный мозг расположен:
- в костях таза (40%);
- в позвонках (28%);
- в костях черепа (13%);
- в ребрах (8%);
- в длинных трубчатых костях рук и ног (8%);
- в грудине (2%).
Как образуются эритроциты?
Образование клеток крови происходит из так называемых стволовых клеток. Они образуются в процессе эмбрионального развития в количестве, достаточном для обеспечения кроветворной функции на протяжении всей жизни человека. Их отличительной особенностью является способность размножаться (делиться) с образованием клонов, которые могут превращаться в любую клетку крови.При делении стволовой клетки образуются:
- Клетки-родоначальники миелопоэза. В зависимости от потребностей организма они могут делиться с образованием одной из клеток крови - эритроцита, тромбоцита (отвечающего за остановку кровотечений) или лейкоцита (обеспечивающего защиту организма от инфекций).
- Клетки-родоначальники лимфопоэза. Из них формируются лимфоциты, обеспечивающие иммунитет (защитную функцию).
Данный процесс включает в себя несколько последовательных делений, в результате которых клетка уменьшается в размерах, теряет ядро и накапливает гемоглобин.
Для образования эритроцитов необходимы:
- Витамины. Такие витамины как В2 (рибофлавин), В6 (пиридоксин), В12 (кобаламин) и фолиевая кислота необходимы для образования нормальных клеток крови. При недостатке данных веществ нарушаются процессы деления и созревания клеток в костном мозге, в результате чего в кровоток выделяются функционально несостоятельные эритроциты.
- Железо. Данный микроэлемент входит в состав гемоглобина и играет основную роль в процессе транспортировки кислорода и углекислого газа эритроцитами. Поступление железа в организм ограничено скоростью его всасывания в кишечнике (1 – 2 миллиграмма в сутки).
В результате увеличения количества эритроцитов в крови улучшается доставка кислорода к тканям. Это угнетает процесс выделения эритропоэтина почками и уменьшает его влияние на клетку-предшественницу миелопоэза, что тормозит образование эритроцитов в красном костном мозге.
Как разрушаются эритроциты?
В среднем эритроцит циркулирует в крови от 90 до 120 дней, после чего его поверхность деформируется, становится более жесткой. В результате этого он задерживается и разрушается в селезенке (основном органе, в котором происходит разрушение клеток крови), так как не в состоянии пройти через ее капилляры.В процессе разрушения эритроцита железо, входящее в состав гемоглобина, выделяется в кровоток и специальными белками транспортируется в красный костный мозг, где вновь принимает участие в формировании новых эритроцитов. Данный механизм чрезвычайно важен для поддержания процесса кроветворения, требующего в норме от 20 до 30 миллиграмма (мг) железа в сутки (в то время как с пищей всасывается всего лишь 1 – 2 мг).
Что такое эритремия?
 Как упоминалось ранее, эритремия – опухолевый процесс, характеризующийся нарушением деления клетки-предшественницы миелопоэза. Это происходит в результате мутации различных генов, которые в норме регулируют рост и развитие клеток крови.
Как упоминалось ранее, эритремия – опухолевый процесс, характеризующийся нарушением деления клетки-предшественницы миелопоэза. Это происходит в результате мутации различных генов, которые в норме регулируют рост и развитие клеток крови.Возникновение и развитие эритремии
В результате мутаций происходит образование аномального клона данной клетки. Он обладает такими же способностями к дифференцировке (то есть может превращаться в эритроцит, тромбоцит либо лейкоцит), однако неподконтролен регуляторным системам организма, поддерживающим постоянный клеточный состав крови (его деление происходит без участия эритропоэтина или других факторов роста).Мутантная клетка-предшественница миелопоэза начинает интенсивно размножаться, проходя при этом все описанные выше стадии роста и развития, а результатом этого процесса является появление в крови абсолютно нормальных и функционально состоятельных эритроцитов.
Таким образом, в красном костном мозге появляется два разных вида клеток-предшественниц эритроцитов - нормальные и мутантные. В результате интенсивного и неконтролируемого образования эритроцитов из мутантной клетки количество их в крови значительно увеличивается, превышая потребности организма. Это, в свою очередь, угнетает выделение эритропоэтина почками, что приводит к снижению его активирующего влияния на нормальный процесс эритропоэза, однако никак не влияет на опухолевую клетку.
Кроме того, по мере прогрессирования заболевания количество мутантных клеток в костном мозге увеличивается, что приводит к вытеснению нормальных кроветворных клеток. В результате наступает момент, когда все (или почти все) эритроциты организма образуются из опухолевого клона клетки-предшественницы миелопоэза.
При эритремии большинство мутантных клеток превращается в эритроциты, однако определенная их часть развивается по другому пути (с образованием тромбоцитов или лейкоцитов). Этим объясняется увеличение не только эритроцитов, но и других клеток, предшественником которых является клетка-родоначальница миелопоэза. С течением заболевания количество тромбоцитов и лейкоцитов, образующихся из опухолевой клетки, также увеличивается.
Течение эритремии
Вначале эритремия никак не проявляется и почти не влияет на систему крови и на организм в целом, однако по мере прогрессирования заболевания могут развиваться определенные осложнения и патологические состояния.В развитии эритремии условно выделяют:
- начальную стадию;
- эритремическую стадию;
- анемическую (терминальную) стадию.
Может длиться от нескольких месяцев до десятилетий, никак себя не проявляя. Характеризуется умеренным увеличением количества эритроцитов (5 – 7 х 1012 в 1 литре крови) и гемоглобина.
Эритремическая стадия
Характеризуется увеличением числа эритроцитов, образующихся из аномальной клетки-предшественницы (более 8 х 1012 в 1 литре крови). В результате дальнейших мутаций опухолевая клетка начинает дифференцироваться в тромбоциты и лейкоциты, обуславливая увеличение их количества в крови.
Следствием этих процессов является переполнение кровью сосудов и всех внутренних органов. Кровь становится более вязкой, скорость прохождения ее по сосудам замедляется, что способствует активации тромбоцитов прямо в сосудистом русле. Активированные тромбоциты связываются друг с другом, образуя так называемые тромбоцитарные пробки, которые закупоривают просветы мелких сосудов, нарушая ток крови по ним.
Кроме того, в результате увеличения количества клеток в крови происходит усиленное их разрушение в селезенке. Результатом данного процесса является чрезмерное поступление в кровь продуктов клеточного распада (свободного гемоглобина, пуринов).
Анемическая стадия
При прогрессировании заболевания в костном мозге начинается процесс фиброза – замещения кроветворных клеток фиброзной тканью. Кроветворная функция костного мозга постепенно уменьшается, что приводит к снижению количества эритроцитов, лейкоцитов и тромбоцитов в крови (вплоть до критических значений).
Результатом этого процесса является появление экстрамедуллярных очагов кроветворения (вне костного мозга) – в селезенке и печени. Эта компенсаторная реакция направлена на поддержание нормального количества клеток крови.
Кроме того, появление экстрамедуллярных очагов кроветворения может быть обусловлено выходом опухолевых клеток из костного мозга и миграцией их с током крови в печень и селезенку, где они задерживаются в капиллярах и начинают интенсивно размножаться.
Причины эритремии
 Причины эритремии, как и большинства опухолевых заболеваний крови, точно не установлены. Существуют определенные предрасполагающие факторы, которые могут повышать риск возникновения данного недуга.
Причины эритремии, как и большинства опухолевых заболеваний крови, точно не установлены. Существуют определенные предрасполагающие факторы, которые могут повышать риск возникновения данного недуга.Возникновению эритремии могут способствовать:
- генетическая предрасположенность;
- ионизирующая радиация;
- токсические вещества.
Генетическая предрасположенность
На сегодняшний день не удалось установить генные мутации, которые непосредственно приводят к развитию эритремии. Однако генетическую предрасположенность доказывает тот факт, что частота встречаемости данного заболевания у лиц, страдающих определенными генетическими заболеваниями, значительно выше, чем в общей популяции.Риск развития эритремии повышен при:
- Синдроме Дауна – генетическом заболевании, проявляющемся нарушением формы лица, шеи, головы и отставанием ребенка в развитии.
- Синдроме Клайнфельтера – генетическом заболевании, проявляющемся в период полового созревания и характеризующемся непропорциональным развитием тела (высоким ростом, длинными и тонкими руками и ногами, длинной талией), а также возможными умственными отклонениями.
- Синдроме Блума – генетическом заболевании, характеризующемся низким ростом, гиперпигментацией кожи, непропорциональным развитием лица и предрасположенностью к опухолям различных органов и тканей.
- Синдроме Марфана - генетическом заболевании, при котором нарушается развитие соединительной ткани организма, что проявляется высоким ростом, длинными конечностями и пальцами, нарушением зрения и сердечно-сосудистой системы.
Ионизирующая радиация
Радиационное излучение (рентгеновские или гамма-лучи) частично поглощаются клетками живого организма, вызывая повреждения на уровне их генетического аппарата. Это может приводить как к гибели клетки, так и к возникновению определенных мутаций ДНК (дезоксирибонуклеиновой кислоты), ответственной за реализацию генетически запрограммированной функции клетки.Наиболее сильному воздействию радиации подвергаются люди, находящиеся в зонах взрыва атомных бомб, катастроф на атомных электростанциях, а также больные злокачественными опухолями, у которых в качестве лечения применялись различные методы радиотерапии.
Токсические вещества
Вещества, способные при попадании в организм вызывать мутации на уровне генетического аппарата клеток, называются химическими мутагенами. Их роль в развитии эритремии доказана многочисленными исследованиями, в результате которых было выявлено, что люди, больные эритремией, в прошлом контактировали с данными веществами.Химическими мутагенами, приводящими к возникновению эритремии, являются:
- Бензол – входит в состав бензина, химических растворителей.
- Цитостатические медикаменты – азатиоприн, метотрексат, циклофосфан.
- Антибактериальные препараты – хлорамфеникол (левомицетин).
Симптомы эритремии
 Симптомы эритремии различаются, в зависимости от стадии болезни. В то же время, некоторые из них могут присутствовать в течение всего заболевания.
Симптомы эритремии различаются, в зависимости от стадии болезни. В то же время, некоторые из них могут присутствовать в течение всего заболевания.Симптомы начальной стадии
Вначале заболевание протекает без каких-либо особых проявлений. Симптомы эритремии на этой стадии неспецифичны, могут появляться при других патологиях. Их возникновение более характерно для пожилых людей.Проявлениями начальной стадии эритремии могут быть:
- Покраснение кожи и слизистых оболочек. Происходит в результате увеличения количества эритроцитов в сосудах. Покраснение отмечается на всех участках тела, в области головы и конечностей, слизистой полости рта, оболочек глаз. На начальной стадии заболевания данный симптом может быть слабо выражен, в результате чего розоватый оттенок кожных покровов часто принимается за норму.
- Боли в пальцах рук и ног. Данный симптом обусловлен нарушением тока крови по мелким сосудам. На начальной стадии это в большей степени обусловлено повышенной вязкостью крови из-за увеличения количества клеточных элементов. Нарушение доставки кислорода к органам приводит к развитию тканевой ишемии (кислородному голоданию), что проявляется приступами жгучей боли.
- Головные боли. Неспецифический симптом, который, однако, может быть весьма выражен в начальной стадии заболевания. Частые головные боли могут возникать в результате нарушения циркуляции крови в мелких сосудах мозга.
Симптомы эритремической стадии
Клинические проявления второй стадии заболевания обусловлены увеличением количества клеток в крови (в результате чего она становится более вязкой), усиленным разрушением их в селезенке, а также нарушениями свертывающей системы крови.Симптомами эритремической стадии являются:
- покраснение кожных покровов;
- эритромелалгии;
- некрозы пальцев рук и ног;
- увеличение артериального давления;
- увеличение печени;
- увеличение селезенки;
- кожный зуд;
- повышенная кровоточивость;
- боли в суставах;
- язвы органов желудочно-кишечной системы;
- симптомы дефицита железа;
- тромботические инсульты;
- инфаркт миокарда;
- дилатационная кардиомиопатия.
Механизм развития такой же, как и в начальной стадии, однако цвет кожных покровов может приобретать багрово-синюшный оттенок, могут появиться точечные кровоизлияния в области слизистых оболочек (в результате разрыва мелких сосудов).
Эритромелалгии
Причины данного явления точно не установлены. Считается, что оно связано с нарушением циркуляции крови в мелких периферических сосудах. Проявляется резко возникающими приступами покраснения и острой, жгучей боли в области кончиков пальцев рук и ног, мочек ушей, кончика носа.
Обычно поражение носит двусторонний характер. Приступы могут длиться от нескольких минут до нескольких часов. Некоторое облегчение наступает при погружении пораженного участка в холодную воду. По мере прогрессирования основного заболевания зоны болезненности могут увеличиваться, распространяясь на кисть, стопу.
Некрозы пальцев рук и ног
Увеличение количества образующихся тромбоцитов (характерное для этой стадии заболевания), а также замедление тока крови из-за увеличения ее вязкости, способствует образованию тромбоцитарных пробок, закупоривающих мелкие артерии.
Описанные процессы приводят к местным нарушениям кровообращения, что клинически проявляется болезненностью, которая впоследствии сменяется нарушением чувствительности, понижением температуры и отмиранием тканей в пораженной области.
Увеличение артериального давления
Возникает из-за увеличения общего объема циркулирующей крови (ОЦК) в сосудистом русле, а также в результате повышенной вязкости крови, что обуславливает увеличение сосудистого сопротивления кровотоку. Артериальное давление повышается постепенно, по мере прогрессирования заболевания. Клинически это может проявляться повышенной утомляемостью, головными болями, нарушением зрения и другими симптомами.
Увеличение печени (гепатомегалия)
Печень является растяжимым органом, в норме депонирующим до 450 миллилитров крови. При увеличении ОЦК кровь переполняет печеночные сосуды (в ней может задерживаться более 1 литра крови). При миграции опухолевых клеток в печень либо при развитии в ней очагов экстрамедуллярного кроветворения орган может достигать огромных размеров (десять и более килограмм).
Клиническими проявлениями гепатомегалии являются тяжесть и боли в правом подреберье (возникающие из-за чрезмерного растяжения капсулы печени), нарушения пищеварения, нарушение дыхания.
Увеличение селезенки (спленомегалия)
Из-за увеличения ОЦК происходит переполнение селезенки кровью, что со временем приводит к увеличению размеров и уплотнению органа. Также этому процессу способствует развитие патологических очагов кроветворения в селезенке. В увеличенном органе более интенсивно происходят процессы разрушения клеток крови (эритроцитов, тромбоцитов, лейкоцитов).
Кожный зуд
Появление данного симптома вызвано влиянием особого биологически активного вещества – гистамина. В нормальных условиях гистамин содержится в лейкоцитах и высвобождается только при определенных патологических состояниях, чаще аллергического характера.
При длительном течении заболевания происходит увеличение количества лейкоцитов, образующихся из опухолевой клетки. Это приводит к более интенсивному их разрушению в селезенке, в результате чего в кровоток попадает большое количество свободного гистамина, который, помимо прочих эффектов, вызывает сильный кожный зуд, усиливающийся при контакте с водой (при мытье рук, приеме ванны, попадании под дождь).
Повышенная кровоточивость
Может возникать как в результате повышения давления и ОЦК, так и в результате избыточной активации тромбоцитов в сосудистом русле, что приводит к их истощению и нарушению свертывающей системы крови. Для эритремии характерны длительные и обильные кровотечения из десен после удаления зубов, после небольших порезов и травм.
Боли в суставах
В связи с усиленным разрушением клеток крови в кровоток попадает большое количество продуктов их распада, в том числе пуринов, входящих в состав нуклеиновых кислот (генетического аппарата клеток). В нормальных условиях пурины превращаются в ураты (соли мочевой кислоты), которые выделяются с мочой.
При эритремии количество образуемых уратов увеличено (развивается уратовый диатез), в результате чего они оседают в различных органах и тканях. Со временем происходит их накопление в суставах (сперва в мелких, а затем и в более крупных). Клинически это проявляется покраснением, болезненностью и ограничением подвижности в пораженных суставах.
Язвы органов желудочно-кишечной системы
Их возникновение связано с нарушением циркуляции крови в слизистой оболочки желудка и кишечника, что значительно снижает ее барьерные функции. В результате кислый желудочный сок и пища (особенно острая или грубая, плохо обработанная) травмирует слизистую, способствую развитию язв.
Клинически данное состояние проявляется болями в животе, возникающими после еды (при язве желудка), либо натощак (при язве двенадцатиперстной кишки). Другими проявлениями являются изжога, тошнота и рвота после приема пищи.
Симптомы дефицита железа
Как упоминалось ранее, количество железа, поступающего в организм с пищей, ограниченно скоростью всасывания его в кишечнике и составляет 1 – 2 мг в сутки. В нормальных условиях в организме человека содержится 3 – 4 грамма железа, при этом 65 – 70% входит в состав гемоглобина.
При эритремии большая часть поступающего в организм железа (до 90 – 95%) используется для образования эритроцитов, результатом чего является недостаток данного элемента в других органах и тканях.
Проявлениями дефицита железа являются:
- сухость кожи и слизистых оболочек;
- истончение и повышенная ломкость волос;
- трещины в углах рта;
- расслаивание ногтей;
- отсутствие аппетита;
- нарушение пищеварения;
- нарушение вкуса и обоняния;
- снижение сопротивляемости инфекциям.
Инсульт (острое нарушение кровообращения в определенном участке головного мозга) также развивается в результате образования тромбов в сосудистом русле. Проявляется внезапной потерей сознания и различными неврологическими симптомами (в зависимости от области мозга, в которой нарушен кровоток). Является одним из наиболее опасных осложнений эритремии и без срочной медицинской помощи может привести к смертельному исходу.
Инфаркт миокарда
Механизм возникновения инфаркта такой же, как при инсульте - образующиеся тромбы могут закупоривать просвет кровеносных сосудов, питающих сердце. Так как компенсаторные возможности данного органа крайне малы, в нем очень быстро истощаются запасы кислорода, что приводит к некрозу сердечной мышцы.
Инфаркт проявляется внезапным приступом сильнейшей, острой боли в области сердца, которая длится более 15 минут и может распространяться на левое плечо и в область спины слева. Данное состояние требует срочной госпитализации и оказания квалифицированной медицинской помощи.
Дилатационная кардиомиопатия
Данным термином обозначается нарушение работы сердца, связанное с увеличением объема циркулирующей крови. При переполнении камер сердца кровью постепенно происходит растяжение органа, что является компенсаторной реакцией, направленной на поддержание кровообращения. Однако компенсаторные возможности данного механизма ограничены, и при их истощении сердце растягивается слишком сильно, в результате чего утрачивает способность к нормальным, полноценным сокращениям.
Клинически данное состояние проявляется общей слабостью, повышенной утомляемостью, болями в области сердца и нарушениями сердечного ритма, отеками.
Симптомы анемической стадии
Третья стадия эритремии также называется терминальной, развивается при отсутствии соответствующего лечения в первой и второй стадиях и часто заканчивается смертельным исходом. Характеризуется уменьшением образования всех клеток крови, что и обуславливает клинические проявления.Основными проявлениями терминальной стадии эритремии являются:
- кровотечения;
- анемия.
Появляются спонтанно либо при минимальной травматизации кожи, мышц, суставов и могут длиться от нескольких минут до нескольких часов, представляя опасность для жизни человека. Характерными признаками являются повышенная кровоточивость кожи и слизистых оболочек, кровоизлияния в мышцы, суставы, кровотечения желудочно-кишечной системы и т. д.
Возникновение кровотечений в терминальной стадии обусловлено:
- уменьшением образования тромбоцитов;
- образованием функционально несостоятельных тромбоцитов.
Данное состояние характеризуется снижением уровня гемоглобина в крови, которому часто сопутствует уменьшение количества эритроцитов.
Причинами анемии в терминальной стадии заболевания могут быть:
- Угнетение кроветворения в костном мозге. Причиной этого является разрастание соединительной ткани (миелофиброз), которая полностью вытесняет кроветворные клетки из костного мозга. В результате развивается так называемая апластическая анемия, проявляющаяся снижением уровня эритроцитов, тромбоцитов и лейкоцитов.
- Дефицит железа. Недостаток данного микроэлемента ведет к нарушению образования гемоглобина, в результате чего в кровь поступают большие, функционально несостоятельные эритроциты.
- Частые кровотечения. В данном случае скорость образования новых клеток крови недостаточна, чтобы восполнить потери, возникающие при кровотечениях. Эта ситуация еще более усугубляется дефицитом железа.
- Усиленное разрушение эритроцитов. В увеличенной селезенке задерживается большое количество эритроцитов и тромбоцитов, которые со временем разрушаются, обуславливая развитие анемии.
- бледность кожи и слизистых оболочек;
- общая слабость;
- повышенная утомляемость;
- чувство нехватки воздуха (особенно при физических нагрузках);
- частые обмороки.
Диагностика эритремии
 Диагностикой и лечением данного недуга занимается врач-гематолог. Заподозрить заболевание можно, основываясь на его клинических проявлениях, однако для подтверждения диагноза и назначения соответствующего лечения необходимо провести ряд дополнительных лабораторных и инструментальных исследований.
Диагностикой и лечением данного недуга занимается врач-гематолог. Заподозрить заболевание можно, основываясь на его клинических проявлениях, однако для подтверждения диагноза и назначения соответствующего лечения необходимо провести ряд дополнительных лабораторных и инструментальных исследований.В диагностике эритремии применяются:
- общий анализ крови;
- биохимический анализ крови;
- пункция костного мозга;
- лабораторные маркеры;
- инструментальные исследования.
Общий анализ крови
Наиболее простой, и в то же время один из самых информативных лабораторных тестов, позволяющих быстро и точно определить клеточный состав периферической крови. Общий анализ крови (ОАК) назначают всем пациентам, у которых заподозрен хотя бы один из симптомов эритремии.Забор крови для анализа производится утром, натощак, в специально оборудованном кабинете. Как правило, кровь берут из безымянного пальца левой руки. Предварительно обработав кончик пальца ватой, смоченной спиртом, специальной иглой производят прокол кожи на глубину 2 – 4 мм. Первую образовавшуюся каплю крови стирают ватным тампоном, после чего в специальную пипетку набирают несколько миллилитров крови.
Полученная кровь переносится в пробирку и отправляется в лабораторию для дальнейшего исследования.
Основными параметрами, исследуемыми при ОАК, являются:
- Количество клеток крови. Отдельно подсчитывается количество эритроцитов, тромбоцитов и лейкоцитов. На основании количества клеток в исследуемом материале делаются выводы об их количестве в сосудистом русле.
- Количество ретикулоцитов. Их количество определяется по отношению к общему числу эритроцитов и выражается в процентах. Дает информацию о состоянии кроветворения в костном мозге.
- Общее количество гемоглобина.
- Цветовой показатель. Данный критерий позволяет определить относительное содержание гемоглобина в эритроците. В норме в одном эритроците содержится от 27 до 33,3 пикограмм (пг) гемоглобина, что характеризуется цветовым показателем, равным 0,85 – 1,05 соответственно.
- Гематокрит. Отображает долю клеточных элементов по отношению к общему объему крови. Выражается в процентах.
- Скорость оседания эритроцитов (СОЭ). Определяется время, в течение которого произойдет разделение клеток крови и плазмы. Чем больше эритроцитов в объеме крови, тем сильнее они отталкиваются друг от друга (из-за отрицательно заряженных поверхностей клеточных мембран), и тем медленнее будет СОЭ.
Изменения общего анализа крови, в зависимости от стадии эритремии
| Показатель | Норма | Начальная стадия | Эритремическая стадия | Анемическая стадия |
| Количество эритроцитов | Мужчины (М): 4,0 – 5,0 х 1012/л | 5,7 – 7,5 х 1012/л | более 8 х 1012/л | менее 3 х 1012/л |
| Женщины (Ж): 3,5 – 4,7 х 1012/л | 5,2 – 7 х 1012/л | более 7,5 х 1012/л | менее 2,5 х 1012/л | |
| Количество тромбоцитов | 180 – 320 х 109/л | 180 – 400 х 109/л | более 400 х 109/л | менее 150 х 109/л |
| Количество лейкоцитов | 4,0 – 9,0 х 109/л | не изменено | более 12 х 109/л (при отсутствии инфекции или интоксикации) | менее 4,0 х 109/л |
| Количество ретикулоцитов | М: 0,24 – 1,7% | не изменено | более 2% | может быть нормальным, повышенным или пониженным |
| Ж: 0,12 – 2,05% | не изменено | более 2,5% | ||
| Общее количество гемоглобина | М: 130 – 170 г/л | 130 – 185 г/л | более 185 г/л | менее 130 г/л |
| Ж: 120 – 150 г/л | 120 – 165 г/л | более 165 г/л | менее 120 г/л | |
| Цветовой показатель | 0,85 – 1,05 | не изменен | менее 0,8 | может быть нормальным, повышенным или пониженным |
| Гематокрит | М: 42 – 50% | 42 – 52% | 53 – 60% и выше | менее 40% |
| Ж: 38 – 47% | 38 – 50% | 51 – 60% и выше | менее 35% | |
| Скорость оседания эритроцитов | М: 3 – 10мм/час | 2 – 10 мм/час | 0 – 2мм/час | более 10мм/час |
| Ж: 5 – 15мм/час | 3 – 15 мм/час | 0 – 3 мм/час | более 15мм/час |
Биохимический анализ крови
Лабораторное исследование, с помощью которого можно определить количество определенных веществ в крови.Забор крови для биохимического анализа производится из локтевой или лучевой подкожных вен руки, располагающихся на передней поверхности локтевого сгиба. Пациент садится на стул и кладет руку на его спинку. Медсестра перевязывает жгутом руку пациента на 10 – 15 см выше локтевого сгиба, и просит его «поработать кулаком» – сжимать и разжимать пальцы руки (это увеличит приток крови к венам и облегчит процедуру).
Определив расположение вены, медсестра тщательно обрабатывает место будущего прокола ватой, смоченной в спирте, после чего вводит в вену иглу, подсоединенную к шприцу. Убедившись, что игла находится в вене, медсестра снимает жгут и производит забор нескольких миллилитров крови. Игла выводится из вены, на место прокола на 5 – 10 минут прикладывается вата, пропитанная спиртом.
Полученный материал переносится в специальную пробирку и отправляется в лабораторию для дальнейшего исследования.
При эритремии определяют:
- Количество железа в крови.
- Печеночные пробы. Из печеночных проб наиболее информативно определение уровня аланинаминотрансферазы (АлАТ) и аспартатаминотрансферазы (АсАТ). Данные вещества содержаться в клетках печени и высвобождаются в кровь в больших количествах при их разрушении.
- Билирубин (непрямая фракция). При разрушении эритроцита из него выделяется пигмент билирубин (непрямая или несвязанная фракция). В печени данный пигмент быстро связывается с глюкуроновой кислотой (образуется прямая, связанная фракция) и выводится из организма. Таким образом, оценка непрямой фракции билирубина дает информацию о выраженности процесса разрушения эритроцитов в организме.
- Количество мочевой кислоты в крови.
Изменения биохимического анализа крови при эритремии
| Показатель | Норма | Начальная стадия | Эритремическая стадия | Анемическая стадия |
| Количество железа в крови | М: 17,9 – 22,5 мкмоль/л | не изменено | в норме или снижено | снижено |
| Ж: 14,3 – 17,9 мкмоль/л | ||||
| Количество АлАТ и АсАТ в крови | М: до 41 Ед/л | не изменено | более 45 Ед/л (до нескольких сотен) | нормальное или слегка повышено |
| Ж: до 31 Ед/л | более 35 Ед/л (до нескольких сотен) | |||
| Билирубин (непрямая фракция) | 4,5 – 17,1 мкмоль/л | 4,5 – 20 мкмоль/л | более 20 мкмоль/л | в норме |
| Количество мочевой кислоты в крови | 2,5 – 8,3 ммоль/л | в норме | более 10 ммоль/л | в норме или увеличено |
Пункция костного мозга
Данный метод широко применяется в диагностике эритремии, так как дает информацию о составе и функциональном состоянии всех видов кроветворных клеток в костном мозге. Суть метода заключается во введении вглубь кости специальной полой иглы с острым концом и заборе материала костного мозга с последующим изучением его под микроскопом. Чаще пунктируют грудину, реже – подвздошную кость таза, ребро или остистый отросток позвонка.Техника выполнения довольно проста, но, в то же время, болезненна для пациента (проводится без обезболивания, так как оно может исказить полученные данные) и сопряжена с определенными рисками (проколом грудины и травматизацией легких, сердца, крупных кровеносных сосудов). Поэтому выполнять процедуру должен опытный врач и только в стерильных условиях операционной.
Место будущей пункции тщательно дезинфицируют раствором спирта или йодом, после чего специальной иглой, расположенной по центру и под прямым углом к грудине, прокалывают кожу и надкостницу на глубину 10 – 12 мм, попадая при этом в полость кости. К игле присоединяют шприц и оттягиванием поршня набирают от 0,5 до 1 мл вещества костного мозга, после чего, не отсоединяя шприц, выводят иглу из кости. Место прокола закрывается стерильным тампоном и заклеивается пластырем.
Вещество костного мозга сворачивается быстрее, чем периферическая кровь, поэтому полученный материал сразу же переносится на предметное стекло, на котором мазок окрашивается специальным красителем и фиксируется. В дальнейшем образцы исследуются под микроскопом, а полученные данные представляются в виде таблицы или диаграммы, которая называется миелограммой.
При микроскопическом исследовании оценивается:
- Количество клеток в костном мозге. При этом вначале определяется их общее число, а затем производится количественный и процентный подсчет клеток каждого из ростков - эритроидного, тромбоцитарного (мегакариоцитарного) и лейкоцитарного.
- Наличие очагов раковых клеток.
- Наличие очагов разрастания соединительной ткани (признаки фиброза).
Изменения миелограммы при эритремии
| Стадия заболевания | Характеристика миелограммы |
| Начальная стадия |
|
| Эритремическая стадия |
|
| Анемическая стадия |
|
Лабораторные маркеры
Определенные анализы дают более подробную информацию о функциональном состоянии системы кроветворения в костном мозге.В диагностике эритремии применяются:
- определение общей железосвязывающей способности сыворотки;
- определение уровня эритропоэтина
Часть железа, циркулирующего в крови, связана со специальным белком – трансферрином, на поверхности которого имеются определенные активные центры, к которым может присоединяться железо. Данный белок образуется в печени и выполняет транспортную функцию, доставляя всасывающееся в кишечнике железо к различным органам и тканям.
В номе около 33% активных центров трансферрина связано с железом, остальные 2/3 остаются свободными. При дефиците данного микроэлемента печенью вырабатывается большее количество трансферрина, что позволяет фиксировать больше железа. Напротив, при избытке железа в организме оно связывается с большим числом свободных активных центров трансферрина, в результате чего их количество уменьшается.
Суть метода заключается в постепенном добавлении к исследуемой крови раствора, содержащего железо, до тех пор, пока все свободные активные центры трансферрина не окажутся связанными. В зависимости от количества железа, необходимого для полного насыщения трансферрина, делаются выводы о дефиците или избытке данного микроэлемента в организме.
Для проведения исследования необходимо:
- исключить прием пищи за 8 часов до сдачи крови;
- исключить прием алкоголя и курение табака за 24 часа до сдачи крови;
- исключить физические нагрузки за 1 час до сдачи крови.
Нормальное значение ОЖСС может колебаться в зависимости от времени суток, физической активности и приема пищи, однако в среднем находится в пределах от 45 до 77 мкмоль/л.
Эритремия характеризуется:
- В начальной стадии – умеренным повышением ОЖСС в результате усиленного образования эритроцитов в костном мозге.
- В эритремической стадии – выраженным повышением ОЖСС, обусловленном дефицитом железа в организме.
- В анемической стадии – может определяться как понижение ОЖСС (при выраженных кровотечениях), так и ее повышение (при фиброзе костного мозга и нарушении образования эритроцитов).
Данное исследование позволяет определить состояние кроветворной системы, а также косвенно указывает на количество эритроцитов в крови.
С целью определения уровня эритропоэтина применяется метод иммуноферментного анализа (ИФА). Суть метода заключается в выявлении искомого вещества (антигена) в крови при помощи специфических антител, взаимодействующих только с этим веществом. Антигеном в данном случае является эритропоэтин.
Методика проведения ИФА состоит из нескольких последовательных этапов. На первом этапе исследуемую кровь помещают в так называемые «лунки», состоящими из специального вещества, к которому может фиксироваться искомый антиген (эритропоэтин).
В лунки добавляется раствор, содержащий антитела к эритропоэтину. Происходит образование комплексов антиген-антитело, которые прочно фиксированы на поверхности лунки. К поверхности антител заранее прикрепляется особый маркер, который может изменять свой цвет при взаимодействии с определенными веществами (ферментами).
На втором этапе производится промывание лунок специальным раствором, в результате чего удаляются антитела, не соединенные с антигенами. После этого в лунки добавляется особый фермент, который вызывает изменение цвета маркеров, фиксированных на поверхности антител.
На заключительном этапе с помощью специального аппарата производится подсчет количества окрашенных комплексов антиген-антитело, на основании чего делаются выводы о количестве эритропоэтина в исследуемой крови.
Норма эритропоэтина в плазме составляет 10 – 30 мМЕ/мл (международных миллиединиц в 1 миллилитре). В начальной и эритремической стадиях данный показатель снижен, так как большое количество эритроцитов угнетает выработку эритропоэтина почками. В терминальной стадии при развитии анемии количество эритропоэтина в крови значительно превышает норму.
Инструментальные исследования
Помогают в диагностике различных осложнений эритремии.С диагностической целью применяются:
- ультразвуковое исследование (УЗИ) органов брюшной полости;
- допплерография.
Данный метод отличается простотой и безопасностью и с успехом применяется для диагностики увеличения внутренних органов, в первую очередь селезенки и печени.
Метод основан на способности тканей организма по-разному отражать звуковые волны (в зависимости от их плотности и состава). Ультразвуковые волны, отражающиеся от поверхности исследуемого органа, воспринимаются специальным датчиком, и после компьютерной обработки полученных сигналов на мониторе отображаются точные данные о расположении, размерах и консистенции органа.
УЗИ внутренних органов при эритремии характеризуется:
- переполнением кровью всех внутренних органов;
- увеличением размеров селезенки и печени;
- очагами гиперэхогенности в селезенке и печени (соответствующими фибротическим процессам);
- наличием инфарктов в селезенке и печении (зона гиперэхогенности конусовидной формы).
Метод, основанный на принципе ультразвуковых волн, позволяющий определить наличие и скорость кровотока в сосудах различных органов и тканей. При эритремии применяется главным образом для диагностики тромботических осложнений – инсульта, инфаркта селезенки, печени.
Принцип метода заключается в следующем - специальный прибор излучает ультразвуковые волны, которые, отражаясь от крови в исследуемом сосуде, улавливаются приемником, расположенным вблизи источника ультразвука.
Длина и частота отраженных волн будет различной в зависимости от направления тока крови. После компьютерной обработки полученная информация отображается на мониторе. Синим цветом обозначаются участки сосудов, где кровь течет в направлении от источника ультразвука, а красным - по направлению к источнику ультразвука. Это позволяет судить о кровоснабжении исследуемого органа.
При тромбозе сосудов мозга, селезенки, печени и других органов кровоток в них может быть снижен или вовсе отсутствовать (в зависимости от степени перекрытия просвета сосуда тромбом), что подтверждается клиническими проявлениями ишемии данных органов.
Лечение эритремии
 При подтверждении диагноза эритремии важно как можно скорее начать лечение, чтобы предотвратить дальнейшее прогрессирование заболевания и развитие осложнений.
При подтверждении диагноза эритремии важно как можно скорее начать лечение, чтобы предотвратить дальнейшее прогрессирование заболевания и развитие осложнений.Основными направлениями в лечении эритремии являются:
- медикаментозная терапия основного заболевания;
- улучшение текучести крови;
- снижение уровня гемоглобина и гематокрита;
- устранение дефицита железа;
- коррекция уратового диатеза;
- симптоматическая терапия.
Медикаментозная терапия эритремии
Химиотерапия назначается в эритремической стадии заболевания. Целью лечения является уменьшение количества делений мутантной клетки и ее уничтожение, поэтому основными применяемыми препаратами являются цитостатические медикаменты, нарушающие процессы клеточного деления и развития.Данные препараты обладают рядом побочных реакций, наиболее опасной из которых является развитие острых лейкозов. Чтобы снизить риск развития осложнений, лечение следует проводить только в стационаре, строго соблюдая дозировку и режим приема препаратов, под постоянным контролем показателей периферической крови - эритроцитов, тромбоцитов и лейкоцитов.
Показаниями к применению цитостатиков являются:
- быстропрогрессирующее увеличение количества клеток крови (эритроцитов, тромбоцитов и лейкоцитов);
- выраженное увеличение селезенки и печени;
- частые тромботические осложнения (инсульты, инфаркты).
Медикаментозное лечение эритремии
| Название препарата | Механизм лечебного действия | Способы применения и дозы | Оценка эффективности лечения |
| Миелосан (Бусульфан) | Противоопухолевое средство, селективно угнетающее деление клеток-предшественниц миелопоэза. Уменьшает образование эритроцитов, тромбоцитов и лейкоцитов (в большей степени, чем других клеток крови). | Принимать внутрь, после еды, в зависимости от количества лейкоцитов в крови:
| В период лечения необходимо проведение ОАК 1 раз в неделю. В период ремиссии – 1 раз в месяц. Критериями эффективного лечения являются:
|
| Миелобромол | Противоопухолевый препарат, угнетающий кроветворение в красном костном мозге. Назначается при неэффективности миелосана. | Применяется внутрь, перед едой:
| Критерии контроля кроветворения и эффективности лечения такие же, как у миелосана. |
| Гидроксимочевина | Противоопухолевый препарат, нарушающий процессы образования ДНК, что замедляет и останавливает клеточное деление. Особенно эффективен при сочетании эритремии с увеличением количества тромбоцитов. | Принимать внутрь, за час до еды. Начальная доза составляет 500 мг в сутки, разделенная на три приема. При неэффективности суточная доза может быть увеличена до 2000 мг. Принимать до развития ремиссии, после чего переходят на поддерживающую дозу – 500 мг ежедневно. | Критерии контроля кроветворения и эффективности лечения такие же, как у миелосана. |
Улучшение текучести крови
Повышенная вязкость крови приводит к нарушению микроциркуляции, тромбозам мелких сосудов пальцев рук и ног, повышению артериального давления. Своевременная и адекватная коррекция данного состояния важна для предотвращения развития тромботических осложнений. Методы уменьшения вязкости крови
| Медикаментозные методы | ||||
| Название | Механизм лечебного действия | Способ применения и дозы | Контроль эффективности лечения | |
| Ацетилсалициловая кислота (Аспирин) | Противовоспалительное средство. Угнетает синтез определенных ферментов в тромбоцитах, в результате чего снижается их способность к агрегации (связыванию друг с другом и образованию тромбоцитарных сгустков). | С целью уменьшения вязкости крови применяется внутрь, в дозе 125 – 500 мг, 2 – 4 раза в сутки. Максимальная суточная доза 8 г. | Критериями эффективности лечения являются:
| |
| Курантил (Дипиридамол) | Сосудорасширяющий препарат. Улучшает кровоток в периферических сосудах и сосудах сердца (преимущественно в артериях). В комбинации с аспирином усиливает его антиагрегантную активность, уменьшая вероятность образования тромбов. | Принимать внутрь, за 1 час до еды. Начальная доза 75 мг 3 – 6 раз в сутки. При необходимости доза может быть увеличена до 100 мг 3 – 6 раз в сутки. | Критерии эффективности лечения такие же, как у аспирина. | |
| Гепарин | Противосвертывающий препарат, угнетающий активность факторов свертывания крови (тромбина, IXa, Xa, XIa и XIIa факторов). При эритремии применяется, в основном, перед кровопусканиями с целью уменьшения вязкости и улучшения текучести крови. | Вводится внутривенно, за 20 – 30 минут до начала процедуры кровопускания, в дозе 5000 ЕД. | Свертывание крови замедляется почти сразу, что подтверждается соответствующими тестами (увеличением времени свертывания крови, увеличением активированного частичного тромбопластинового времени и другими). | |
| Немедикаментозные методы | ||||
| Название метода | Механизм лечебного действия | Методика выполнения | Контроль эффективности лечения | |
| Кровопускание | Суть метода заключается в искусственном удалении определенного количества крови из сосудистого русла. Так как количество плазмы восстанавливается гораздо быстрее, чем количество клеточных элементов, данный метод приводит к временному снижению вязкости крови и улучшению микроциркуляции. | Специальной иглой, после обработки кожи ватой, смоченной в спиртовом растворе, прокалывается одна из поверхностных вен (чаще локтевой области) и производится забор 150 – 400 мл крови. Процедура повторяется через день. | Критериями эффективности лечения являются:
| |
Снижение уровня гемоглобина и гематокрита
Иногда течение эритремии может характеризоваться значительным увеличением количества эритроцитов при нормальных показателях других клеток крови. В таких случаях лечебная тактика сводится к удалению преимущественно красных клеток крови, что снижает показатели гематокрита и благоприятно влияет на течение заболевания. Методы снижения уровня гемоглобина и гематокрита
| Название метода | Механизм лечебного действия | Методика выполнения | Контроль эффективности лечения |
| Кровопускания | Механизм лечебного действия, методика выполнения и контроль эффективности такие же, как при устранении вязкости крови данным методом. | ||
| Эритроцитаферез | Метод, являющийся альтернативой кровопусканию. Суть его заключается в извлечении из кровотока исключительно эритроцитов, что уменьшает количество гемоглобина и снижает показатели гематокрита. | Процедура проводится в специально оборудованном кабинете. В вену локтевой области устанавливается катетер, который подключается к специальному аппарату. Аппарат производит забор 600 – 800 мл крови, селективно удаляет из нее эритроциты и возвращает в сосудистое русло плазму и другие клеточные элементы крови. Эритроцитаферез проводится 1 раз в неделю, курс лечения – 3 – 5 недель. | Критериями эффективности лечения являются:
|
Устранение дефицита железа
Дефицит железа может развиваться в результате повышенного образования эритроцитов либо являться следствием кровопусканий или эритроцитафереза. В любом случае, независимо от причины, недостаток железа в организме должен быть как можно скорее восполнен, так как данное состояние негативно влияет на течения заболевания. Коррекция дефицита железа проводится препаратами железа. Медикаменты, устраняющие дефицит железа в организме
| Название медикамента | Механизм действия | Способ применения и дозы | Контроль эффективности лечения |
| Феррум Лек | Комплекс железа, входящий в состав данного медикамента, схож с естественным соединением железа в организме (ферритином), в результате чего быстро восстанавливается недостаток данного микроэлемента в организме. | Вводят глубоко внутримышечно. Средняя доза – 100 – 200 мг в стуки. Длительность лечения не менее 4 недель. | Критериями эффективности лечения являются:
|
| Мальтофер | Препарат железа для приема внутрь. Механизм действия такой же, как у препарата Феррум Лек. | Применяется внутрь, во время или сразу после еды, в дозе 100 – 150 мг, 1 – 3 раза в сутки. Таблетку можно разжевывать или глотать целиком. Длительность лечения – 3 – 5 месяцев. Поддерживающая терапия – 100 мг препарата 1 раз в сутки, в течение 2 – 3 месяцев (для восстановления запасов железа в организме). | Критерии эффективности такие же, как у препарата Феррум Лек. |
Коррекция уратового диатеза
Повышенное количество солей мочевой кислоты характеризуется поражением суставов, что может приводить к развитию инвалидности, поэтому лечение данного состояния следует начинать сразу при его обнаружении. Медикаменты, влияющие на обмен уратов в организме
| Название медикамента | Механизм действия | Способ применения и дозы | Контроль эффективности лечения |
| Аллопуринол | Противоподагрическое средство, нарушающее синтез мочевой кислоты в организме, что предотвращает образование уратных отложений в органах и тканях. | Внутрь, после еды. Начальная доза 200 – 400 мг в сутки, разделенная на 2 – 3 приема. При неэффективности доза может быть увеличена до 600 мг в сутки. | Критериями эффективности лечения являются:
|
| Антуран (Сульфинпиразон) | Повышает выделение мочевой кислоты с мочой, что приводит к снижению ее концентрации в крови. | Внутрь, во время еды. Начальная доза 100 – 200 мг, разделенная на 3 – 4 приема. При неэффективности дозу постепенно повышают до максимальной суточной дозы – 800 мг. | Критериями эффективности лечения являются:
|
Симптоматическая терапия
Симптоматическая терапия применяется на всех стадиях эритремии. Целью лечения является коррекция проявлений увеличенного ОЦК, устранение тромботических, а в терминальной стадии – анемических осложнений заболевания.Основными направлениями симптоматической терапии являются:
- Коррекция повышенного артериального давления – антигипертензивные средства (Лизиноприл, Амлодипин).
- Устранение кожного зуда – антигистаминные препараты (Периактин).
- Коррекция анемии – переливание донорской крови, отмытых эритроцитов, тромбоцитов.
- Улучшение работы сердца (при сердечной недостаточности) – сердечные гликозиды (Строфантин, Коргликон).
- Профилактика развития язв желудка – гастропротекторы (Омепразол, Алмагель).
- Коррекция усиленного разрушения клеток крови в селезенке – хирургическое удаление органа (при неэффективности других методов лечения).
- Консультации других специалистов – онколога, невролога, гастролога, ревматолога.
Прогноз при эритремии
 Несмотря на то, что эритремия считается доброкачественным опухолевым заболеванием, без соответствующего лечения она всегда заканчивается смертельным исходом.
Несмотря на то, что эритремия считается доброкачественным опухолевым заболеванием, без соответствующего лечения она всегда заканчивается смертельным исходом.Прогноз при эритремии определяется:
- Своевременной диагностикой – чем раньше выявлено заболевание, тем скорее начнется его лечение, и прогноз будет более благоприятным.
- Адекватной и своевременной терапией – при правильном лечении симптомы заболевания могут полностью исчезать.
- Уровнем эритроцитов, тромбоцитов и лейкоцитов в крови – чем он выше в течение заболевания, тем хуже прогноз.
- Ответом организма на проводимое лечение – в некоторых случаях эритремия прогрессирует, несмотря на проводимые лечебные мероприятия.
- Выраженностью фибротических процессов в костном мозге – чем больше кроветворной ткани останется в костном мозге, тем благоприятнее будет исход заболевания.
- Тромботическими осложнениями – при тромбозах сосудов мозга, сердца, печени, селезенки, легких и других органов прогноз неблагоприятный.
- Скоростью злокачественного перерождения опухоли – эритремия может перейти в острый лейкоз с весьма тяжелым течением и смертельным исходом.